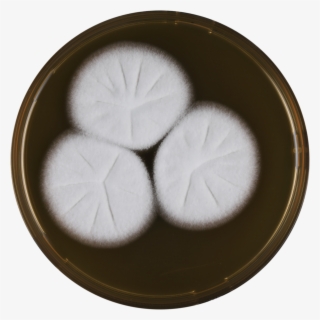
Aspergillus Assulatus Meaox - Dish #8919445

-
Counter Sweets 6 1 - Dish
760*760
3
1
-
Seder Plate Png Svg Transparent Download - Dish
752*750
2
1
-
1 - Side Dish
1080*1309
3
1
-
Taste - Side Dish
960*960
2
1
-
Bacon Cheese Burger - Side Dish
659*659
3
1
-
White - Avanti Dotted Circle Soap Dish - Blue 13870c
1800*1800
3
1
-
Aka Kappa Copy - Dish
1000*1000
3
1
-
Plate3 - Transparent Dirty Dishes
703*720
3
1
-
Meet Kathy And Tracee - Side Dish
987*987
2
1
-
Dishes - Dish
1000*1100
2
1
-
Dish
935*1340
2
1
-
Sub Tray - Side Dish
724*549
3
1
-
Dish
900*750
2
1
-
Dish
1400*395
2
1
-
Spinach & Cheese - Side Dish
574*574
3
1
-
Chicharrones De Calamares - Side Dish
624*550
4
1
-
A La Carte - Side Dish
1341*1981
3
1
-
Dish
783*1794
3
1
-
World Of Emoji's Pillows - Kovot Poop Emoji Ceramic Dish
1000*1000
4
1
-
Dish
915*612
2
1
-
Chef's Favorites - Side Dish
800*800
3
1
-
Event Invite 3 Nov 2014 S - Dish
2473*2519
3
1
-
Glendale Yankee Products Lasagne - Dish
801*797
2
1
-
Crab Rangoon Png - Dish
640*585
2
1
-
Sandwich Clipart Almuerzo - Dish
847*800
2
1
-
6000 X 1500 10 - Dish Sling Tv Logo
6000*1500
2
1
-
Dish
868*478
0
0
-
Chateau Food Products Home Of The World - Dish
1000*542
2
1
-
Gluten-free Meal Plan - Side Dish
1008*648
1
1
-
Se Hace Viral El Video De Lady Cucaracha - Dish
1319*732
2
1
-
Panel1ab-1140x450 - Dish
1140*450
1
1
-
Side Dish
1000*985
2
1
-
Place Setting - Dish
947*721
2
1
-
Golden Moments Crêpe - Dish
879*895
2
1
-
Serve & Enjoy - Side Dish
960*960
2
1
-
Large Spring Roll - Dish
1111*801
2
1
-
Chicken Kebab - Side Dish
3288*3192
2
1
-
Crispy - Chop Suey Dishes Png
916*430
2
1
-
Dish
715*715
1
1
-
Step - Dish
650*1246
1
1
-
Salt & Pepper Potatoes - Side Dish
1266*1030
2
1
-
Item - Dish
1000*1970
2
1
-
Ubereats Logo Png - Skip The Dishes
834*556
2
1
-
Dish
679*479
2
1
-
Just A Platter - Side Dish
650*650
2
1
-
Fish - Side Dish
600*600
2
1
-
Dish
960*540
1
1
-
Turkey Banners - Dish
1000*430
1
1
-
Picture - Dish
816*490
2
1
-
Dish
1800*1800
1
1
-
Thanksgiving Dinner Mamitalks - Dish
700*472
2
1
-
Nabe Cooking Pot - Dish
700*700
2
1
-
Side Dish
2764*2749
2
1
-
Tamales - Tamales2-bogota - Dish
630*630
2
1
-
Buffet - Dish
706*756
2
1
-
Famous 4-egg Omelette - Dish
1380*1102
1
1
-
Hit 100 Programs - Dish
1000*707
1
1
-
Aspergillus Assulatus Meaox - Dish
3573*3573
1
1
-
Meatball Clipart Tree - Little Dish Mouse
600*600
2
1
-
And Sizzling Fajitas - Side Dish
980*643
1
1
-
Photos - Dish
1000*1000
2
1
-
Click To Enlarge - Side Dish
700*500
2
1
-
Dish
600*600
1
1
-
Ribeyeflorentine - Side Dish
1024*683
1
1
-
Ic3 Basketball Shot Trainer - Dr Dish Basketball Trainer
2200*1460
2
1
-
Cooking & Service Items - Chafing Dish
495*645
2
1
-
Dish
767*1365
1
1
-
Wordpress Carousel Free Version - Dish
1000*1000
2
1
-
Side Dish
1158*2165
1
1
-
Mediterranean Rice - Side Dish
1024*1024
1
1
-
Dinner Set - Chafing Dish
1500*1080
2
1
-
Sushi Boat - Dish
1024*681
2
1
-
Dish
901*639
2
1